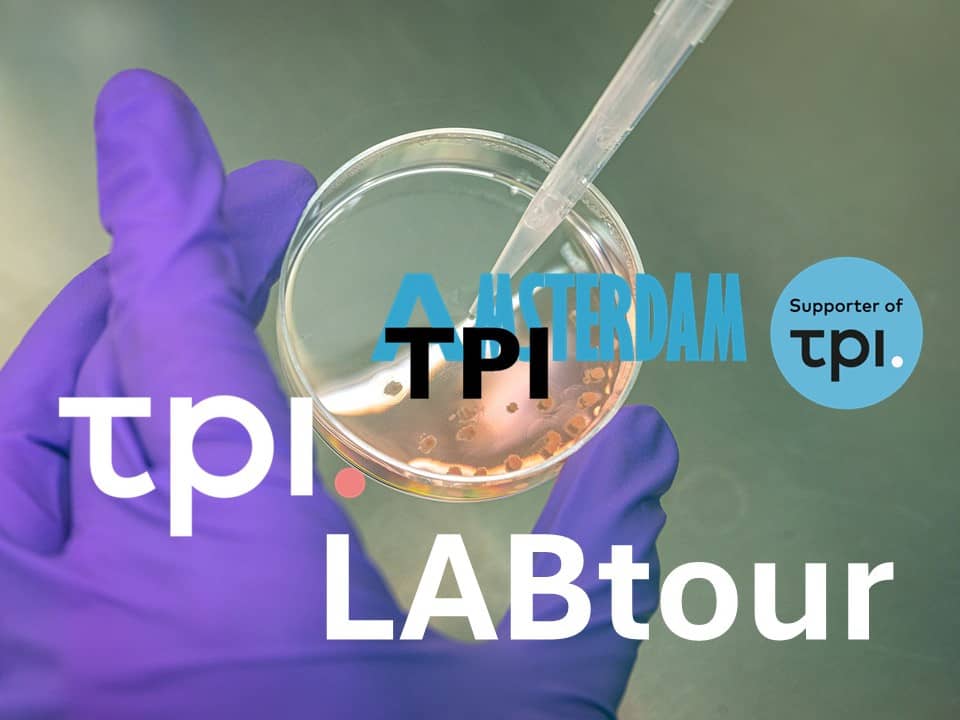

Nederland wil internationaal vooroplopen op het gebied van vernieuwingen (innovaties) die dierproeven overbodig maken. Daarom stimuleert de Rijksoverheid het ontwikkelen en toepassen van methoden voor onderzoek zonder proefdieren. Dit gebeurt met het partnerprogramma Transitie Proefdiervrije Innovatie (TPI).
-
Waarom TPI: missie, visie en doelstellingen
-
Wat TPI doet: kennis delen en dialoog voeren
De partners van TPI
De partners van TPI komen uit overheid, maatschappij, bedrijfsleven en wetenschap. We denken soms verschillend over de transitie naar proefdiervrije innovaties en hebben verschillende kennis in huis. Zo inspireren we elkaar en vullen we elkaar aan.
Iedereen wil een veilige omgeving voor mens, dier en milieu (animatievideo)

Transitie Proefdiervrije Innovatie
afgekort TPI,
is een programma dat de transitie
naar proefdiervrij onderzoek stimuleert.
Een partnerprogramma
waarin ministeries en...
...andere organisaties samenwerken.
Iedereen wil een veilige omgeving
voor mens, dier en milieu.
Daar worden
onder andere dierproeven voor gedaan.
Er is echter veel discussie over
dierproeven, vanwege het dierenleed...
...en omdat de uitkomsten
niet altijd toepasbaar zijn op de mens.
Een konijn is immers geen mens.
Vragen over het menselijk lichaam kun
je soms beter beantwoorden door...
...onderzoek te doen met cellen, weefsels of
gegevens van de mens.
Onze missie is dan ook
beter voorspellen zonder proefdieren.
Maar... proefdiervrije innovatie is
niet hetzelfde...
...als een dierproef één op één vervangen
door een andere methode.
Dat zit zo.
Dierproeven worden doorlopend verbeterd
met behulp van de drie V's.
Vervanging waar dat kan.
Vermindering van
het aantal dieren waar mogelijk.
En Verfijning voor beter dierenwelzijn.
Je zou denken:
Vervanging van dierproeven zit daarbij.
Dat is toch voldoende?
Dat is inderdaad al heel mooi.
Maar TPI kijkt breder:
Wat is het maatschappelijke vraagstuk?
Wat is daarbij de wetenschappelijke vraag?
En hoe kun je die het beste beantwoorden?
Dat kan vaak met nieuwe methoden,
zoals: cellen in een schaaltje.
Cellen die samenwerken als een mini-orgaan.
Of computerprogramma's die testgegevens
van patiënten doorrekenen.
Of een combinatie.
Maar hoe weten we zeker dat die nieuwe methoden goed werken?
We vergelijken ze niet
met de minder betrouwbare dierproeven,
maar met betrouwbare gegevens over mensen.
Op dit moment zijn er voor sommige soorten
onderzoek nog dierproeven nodig.
Maar als er meer proefdiervrije innovaties
komen wordt dat op den duur minder.
Zolang dierproeven bestaan,
moeten we de drie V's blijven toepassen.
BEELDTEKST:
Vervanging
Vermindering
Verfijning
Intussen versnellen
we de transitie waar dat kan door:
informatie, communicatie, subsidies,
bijeenkomsten, netwerken en projecten.
Het gaat om een grote systeemverandering.
Iedereen is daarbij nodig:
onderzoekers, docenten, patiënten,
dierenbeschermers,
bedrijven, bestuurders, politici,
wetgevers en nog veel meer.
We moeten samenwerken
om deze transitie voor elkaar te krijgen.
Dat betekent grenzen verleggen
en verbindingen maken.
De transitie is al in volle gang!
Help je mee?
BEELDTEKST:
HELP JE MEE? TPI.
TPI in verhalen
De Transitie Proefdiervrije Innovatie (TPI) is breed. Er zijn veel mensen bij betrokken. We delen hun verhalen om te ontdekken wat de kansen en zorgen zijn rond proefdiervrije innovatie.
Martijn Nolte
“Proefdiervrij en proefdierwijs zijn beiden nodig om de transitie door te maken.”
Interview met Martijn Nolte, senior programmamanager Meer Kennis met Minder Dieren (MKMD) bij ZonMw.
Nynke Kramer (WUR)
“Noem het gerust ouderwetse academische nerdness, maar het geeft mij altijd weer een kick als een nieuw model blijkt te werken”
Interview met Nynke Kramer, toxicologe aan WUR over computermodellen voor toxicologisch onderzoek.
TPI initiatieven
De TPI-partners ontwikkelen initiatieven om de transitie te versnellen. Ook in het bredere netwerk wordt gewerkt aan proefdiervrije innovaties.
Ombion Centrum voor Proefdiervrije Biomedische Translatie
Ombion is een nationaal centrum voor de valorisatie en verspreiding van proefdiervrije innovaties en expertise dat nieuwe biomedische innovaties wil verbeteren en sneller naar patiënten en gebruikers brengen.
NAMs databases: kennis en expertise delen over proefdiervrij onderzoek
Er zijn steeds meer NAMs databases die kennis en expertise over proefdiervrije innovaties vindbaar en beschikbaar maken voor onderzoekers, biotechnici en betrokken instanties
Tijdlijn: Op weg naar beter voorspellen zonder proefdieren
Nederland wil voorloper zijn op het gebied van versnelling van de transitie met biomedisch onderzoek en medicijntesten zonder het gebruik van dieren. Deze ambitie heeft een lange voorgeschiedenis. De tijdlijn geeft een overzicht van de ontwikkelingen tot nu toe.
Wetenschappers William Russell en Rex Burch introduceren het 3V-principe. Dit stimuleert wereldwijd ontwikkelingen op het terrein van vermindering, verfijning, maar ook vervanging (oftewel alternatieven voor het gebruik) van proefdierproeven. Op basis van de 3V’s maakt Nederland in 1977 de Wet op de dierproeven (Wod).
De 3V’s staan voor:
- vervangen: vervang een dierproef door een methode zonder levende dieren;
- verminderen: gebruik niet meer proefdieren dan nodig;
- verfijnen: voorkom zoveel mogelijk pijn of ongerief bij proefdieren.
Welzijn proefdieren
De 3V’s verbeteren het welzijn van proefdieren. Daarnaast stimuleren ze het ontwikkelen van alternatieven voor dierproeven. In Nederland staan de 3V's in Artikel 1d van de Wet op de dierproeven.
Russel en Burch beschrijven de 3V’s (‘The Three R's’) in de studie The Principles of Humane Experimental Technique (november 1958).
De Wod is de 1e wet in Nederland met regels voor het gebruik van proefdieren. De 3V’s spelen daarin een belangrijke rol: vervang, verminder, en verfijn dierproeven.
Bescherming proefdieren
De Wet op de dierproeven beschermt proefdieren. Zo zijn alleen nog proeven met levende dieren toegestaan wanneer er geen alternatief is. Verboden zijn proeven die ernstige pijn, angst, lijden of blijvende schade veroorzaken bij dieren. Als proefdieren toch nodig zijn, moeten pijn, lijden, angst en blijvende schade worden voorkomen of geminimaliseerd. Ook moeten dierproeven gebeuren onder algehele of plaatselijke verdoving als dat mogelijk is.
Het PAD coördineert en stimuleert onderzoek naar 3V-alternatieven voor dierproeven. Onder meer met subsidies. In dit platform werken maatschappelijke organisaties, onderzoeksinstituten, overheid en het bedrijfsleven samen aan oplossingen.
De 3 taken van het PAD:
- onderzoek stimuleren;
- betrokken ministers adviseren;
- beleid voor alternatieven uitdragen.
PAD adviesorgaan
In 1997 wordt het PAD een adviesorgaan. Een vertegenwoordiger van de wetenschap wordt toegevoegd. ZonMw neemt de subsidieactiviteiten over. ZonMw financiert gezondheidsonderzoek en stimuleert vernieuwing in de gezondheidszorg. Het PAD adviseert de minister van Welzijn, Volksgezondheid en Cultuur (WVC) over het ZonMw-programma Dierproeven begrensd.
Dieren hebben een intrinsieke waarde, een eigen waarde die los staat van hun nut of gebruikswaarde voor de mens. Deze toevoeging in artikel 1a van de Wet op de dierproeven (Wod) moet de positie van proefdieren versterken.
Dieren beschermen
De overheid benoemt nu duidelijk dat dieren beschermd moeten worden en niet alleen dienen als instrument voor de mens.
De Rijksoverheid stimuleert het ontwikkelen van alternatieven voor dierproeven. Bij dierproeven die nog nodig zijn, moet het dierenleed zo klein mogelijk worden. Wetenschappers krijgen hiervoor, en voor alternatieven voor dierproeven, geld uit het subsidieprogramma Dierproeven begrensd.
Subsidie onderzoek alternatieven voor dierproeven
Namens de Rijksoverheid geeft onderzoeksfinancier ZonMw tussen 2000 en 2011 onder meer subsidie aan:
- ontwikkeling website humane-endpoints.info voor opleiding professionals die met proefdieren werken;
- onderzoek werkzaamheid en veiligheid van vaccins zonder of met minder dierproeven;
- verbeteren van huisvesting, voeding en behandeling van proefdieren.
Het kabinet wil het aantal dierproeven terugdringen en richt het Nationaal Kenniscentrum Alternatieven voor Dierproeven (NKCA) op. Dit centrum biedt scholing en deelt onder meer kennis over alternatieven voor dierproeven.
Politieke agenda
Met de kabinetsvisie Alternatieven voor Dierproeven (6 juni 2008) komt het onderwerp hoger op de politieke agenda. De organisatiestructuur voor het uitvoeren van het beleid wordt aangepast. Het NKCA ondersteunt de Interdepartementale Werkgroep Alternatieven voor Dierproeven (IWAD). En een maatschappelijke klankbordgroep brengt expertise in vanuit het bedrijfsleven, wetenschap en de samenleving.
Experimenteel onderzoek met dieren is duur, moeilijk om te herhalen en vaak ingewikkeld. Dat zijn de belangrijkste conclusies van een onderzoek door ZonMw in opdracht van de Rijksoverheid.
Voordelen alternatieve methoden
Dierproeven zijn niet meer vanzelfsprekend de beste methode (‘gouden standaard’) voor fundamenteel, toegepast en wettelijk verplicht onderzoek. Alternatieve methoden hebben veel voordelen:
- kunnen herhaald worden (reproduceerbaar);
- voorspellen beter effecten op mensen;
- zijn ethisch minder omstreden;
- kosteneffectiever: hetzelfde of beter resultaat tegen dezelfde of minder kosten.
Beter sturen
Dit staat in het Rapport Wetenschappelijke Trendanalyse Dierproeven (december 2009) van de Universiteit Utrecht. Het is de 1e systematische analyse over ontwikkelingen rond proefdieren, dierproeven en alternatieven. Hiermee kan de Rijksoverheid het beleid en de financiering voor alternatieven voor dierproeven beter sturen. Tegelijk met dit onderzoek verschijnt ook de Maatschappelijke Trendanalyse Dierproeven.
Bedrijven en onderzoekers blijven dierproeven gebruiken. Alleen door druk van buiten kan dat veranderen. Dat zijn de belangrijkste conclusies van een onderzoek door Athena Instituut en de Vrije Universiteit Amsterdam.
Redenen gebruik dierproeven
Wetenschappers, industrie en instanties die geneesmiddelen beoordelen, geven nu nog de voorkeur aan dierproeven boven alternatieven. Onder meer vanwege:
- industrie: alternatief getest product krijgt minder snel toelating tot markt;
- beoordelaars: evaluatie alternatieve methoden vaak duurder;
- wetenschappers: te weinig geld voor onderzoek naar alternatieven. En wetenschappelijke tijdschriften accepteren minder snel publicaties over alternatieve onderzoeksmethodes.
Nieuwe technieken
Kansrijke technieken die in de toekomst dierproeven kunnen vervangen:
- micro-dosing: kleine hoeveelheden geneesmiddel direct testen op mensen;
- micro-array: geautomatiseerd onderzoek naar erfelijk materiaal op een chip.
Ook maatschappelijk debat, aandacht van media of regels van de overheid kunnen leiden tot nieuwe ontwikkelingen. Dit staat het onderzoek Maatschappelijke Trendanalyse Dierproeven (2009).
Deel A: over de data, maatschappelijke trends, maatschappelijke discussies;
Deel B: uitleg over het trendanalysemode en achtergrondgegevens.
Het aantal dierproeven kan tot 40% verminderen in 2025 als de overheid meer investeert in alternatieve methoden. Dit blijkt uit een studie van onderzoeksfinancier ZonMw.
3 scenario’s
Dit rapport stelt dat er 3 scenario’s mogelijk zijn tot 2025. Deze hangen af van hoeveel geld de Rijksoverheid investeert:
1. Status-quo
Investering blijft gelijk: er verandert niets aan het onderwijs waarin proefdieren worden gebruikt. In dit scenario neemt het gebruik van proefdieren af met minder dan 1%.
2. Lineair
Meer investeringen: en er komen onder meer trainingen in nieuwe onderzoeksmethodes en het lesprogramma in het biomedisch onderwijs verandert. Dit zorgt voor een afname van 25% proefdieren en minder last bij de dieren die nog nodig zijn. Ook dalen de kosten voor onderzoek, volgens het rapport.
3. Exponentieel
Oplopende investeringen: en er komen trainingen voor medewerkers van universiteiten, overheid, regelgevende instanties en bedrijfsleven in nieuwe onderzoeksmethodieken. Dit zorgt voor minstens 40% minder proefdieren, volgens het rapport.
Lees verder in de Businesscase Alternatieven voor dierproeven: ‘Meer kennis met minder proefdieren’ (16 november 2010) van ZonMw.
Het vervangen, verminderen en verfijnen (3V’s) van dierproeven kan beter. Onder meer door de Rijksoverheid en instanties die bijvoorbeeld geneesmiddelen toelaten, beter te laten samenwerken met bedenkers van 3V-methoden. Deze ketenaanpak, voor ontwikkelingen van alternatieven voor dierproeven, is een van de aanbevelingen in een onderzoek van het RIVM.
Kansrijke gebieden voor 3V’s
Het RIVM wijst ook een aantal gebieden aan waar het stimuleren van 3V-methoden kansrijk is. Zoals bij onderzoek naar:
- kanker en andere ziekten;
- geneesmiddelen;
- schadelijke stoffen.
Dit staat in de 2 delen van Programmeringsstudie Alternatieven voor Dierproeven van het RIVM:
Het aantal dierproeven kan verder omlaag. De aanpak daarvan beschrijft de Rijksoverheid in het Actieplan Dierproeven en alternatieven.
Activiteiten
Het actieplan benoemt verschillende activiteiten om het gebruik van dierproeven terug te dringen. Zoals:
Onderwijs
Onderzoekers in opleiding zouden in hun proefschrift aanvullende onderbouwing kunnen opnemen waarom een dierproef noodzakelijk is. Ook moeten ze benoemen wat ze hebben gedaan om de proef te vervangen, verminderen of te verfijnen.
Onderzoek
Met systematisch literatuuronderzoek kunnen wetenschappers vooraf zeer volledig inventariseren wat er al aan onderzoek (inclusief eventuele dierproeven) gedaan is op hun terrein. Dit voorkomt onnodige inzet van proefdieren, maakt eventuele alternatieven inzichtelijk en wat het beste model is voor de onderzoeksvraag.
Kennis delen
Vertegenwoordigers uit onder meer de wetenschap, beleid en industrie delen hun kennis in zogeheten rondetafelgesprekken. Dit moet leiden tot terugdringen van dierproeven.
Lees verder in het Actieplan 2011-2021 Dierproeven en alternatieven van 30 december 2011.
Geld voor het ontwikkelen van nieuwe en het verbeteren van bestaande methoden voor onderzoek zonder proefdieren. Dat biedt het MKMD van ZonMw, die het programma financiert.
Betere gezondheid en zorg
Het uiteindelijke doel van het programma MKMD is beter onderzoek naar gezondheid en gezondheidszorg voor de mens. Het programma bestaat uit meerdere modules. Elke module heeft eigen doelen, randvoorwaarden, eventuele samenwerkingspartners en subsidierondes.
Lees verder over het programma Meer Kennis met Minder Dieren op de website van ZonMw.
Het verminderen van het aantal proefdieren is mogelijk. Maar investeringen hiervoor zullen pas na 2025 effect hebben. Dat blijkt uit een vervolgstudie van adviesbureau Technopolis Group.
Technopolis rekende scenario’s door uit de Businesscase Alternatieven voor dierproeven (16 november 2010) van ZonMw. Enkele conclusies:
- De businesscase 2010 schatte de afname van het aantal dierproeven te hoog in.
- De investeringen hebben pas na 2025 effect: methoden worden dan pas optimaal benut.
- Minder dierproeven lijkt op de langere termijn, dus na 2025 haalbaar.
- Internationale acceptatie van 3V (vervangen, verminderen, verfijnen dierproeven) door vakgenoten en in regels is onzeker.
- Investeringen uit de businesscase kunnen versneld leiden tot minder dierproeven als de overheid het geld effectief, gecoördineerd en gefocust inzet.
Lees verder in de Analyse Businesscase Alternatieven voor Dierproeven (10 juli 2014).
Voortaan mag je alleen als het niet anders kan dieren gebruiken voor wetenschappelijk onderzoek. Deze richtlijn van de Europese Unie voert de Rijksoverheid in Nederland in met de gewijzigde herziene Wod.
Wod biedt meer bescherming proefdieren
In de Wod staan regels die verder gaan dan de richtlijn. De 3V’s spelen daarin een belangrijke rol:
- vervangen: vervang een dierproef door een methode zonder levende dieren;
- verminderen: gebruik niet meer proefdieren dan nodig;
- verfijnen: voorkom zoveel mogelijk pijn of ongerief bij proefdieren.
Met handhaving van deze regels beschermt ook Nederland het welzijn van proefdieren op een hoog niveau.
Lees verder over de wijziging in het Dierproevenbesluit 2014 en de Wod zoals die geldt vanaf 1 juli 2021.
Grondig onderzoek van onder meer wetenschappelijke publicaties (systematic reviews) kan het aantal dierproeven verminderen. Dit blijkt uit een rapport van onderzoeksbureau Tabula Rasa.
Verankeren in onderwijs
In de (bio-)medische opleidingen is nog nauwelijks aandacht voor systematic reviews. Studenten moeten daarom leren om systematisch literatuuronderzoek te doen voorafgaand aan nieuw onderzoek. Dit voorkomt het onnodig gebruik van dierproeven. Ook beveelt het rapport aan dat literatuuronderzoek een onderdeel moet worden van onderzoek waar de overheid geld aan geeft.
Lees verder over de aanbevelingen in het rapport Systematic Reviews in het proefdierdomein van januari 2014.
Grondig onderzoek van eerdere publicaties (systematic review) kan bijdragen aan betere wetenschap. Ook kiezen onderzoekers dan minder vaak voor dierproeven. Dit blijkt uit een enquête van onderzoeksbureau Tabula Rasa.
Meer informatie en hulp
Meer dan de helft van de deelnemers aan de enquête geeft aan dat ze meer informatie en hulp willen. Met name nog niet-gepromoveerde medewerkers hebben behoefte aan vaardigheidstraining om zelf systematic reviews uit te voeren.
Ontbreken tijd, kennis
Onderzoekers geven verschillende redenen voor het niet uitvoeren van literatuuronderzoek:
- onvoldoende tijd of prioriteit;
- niet genoeg kennis om het onderzoek te doen;
- vraagstelling waarbij literatuuronderzoek niet zinvol is.
Lees verder in de enquête Systematic reviews bij dierstudies in onderwijs en onderzoek aan Nederlandse universiteiten en UMC’s (maart 2015).
De Rijksoverheid kan de overgang naar proefdiervrij onderzoek versnellen. Dat vraagt om een omslag in manieren van denken, doen en organiseren. Dit staat in een rapport van de Denktank Aanvullende Financiering alternatieven voor dierproeven.
Aanbevelingen rapport
Enkele aanbevelingen uit het rapport:
- publiceer ook negatieve resultaten van onderzoek: dit scheelt proefdieren in nieuw onderzoek;
- maak een overzicht van proefdiervrij onderzoek: als inspirerende voorbeelden;
- start een fonds dat ontwikkeling alternatieven voor dierproeven steunt;
- start een netwerk voor pioniers in proefdiervrije innovatie.
Lees verder in het rapport In transitie! Nederland internationaal toonaangevend in proefdiervrije innovaties (oktober 2015).
Een deel van de wettelijk verplichte veiligheidstesten met proefdieren voor bijvoorbeeld medicijnen en chemische stoffen kan de Rijksoverheid voor 2025 vervangen. Dat concludeert het Nationaal Comité dierproevenbeleid (NCad) in een advies aan de overheid.
Gebruik nieuwe technieken
Om de veiligheid te bepalen van allerlei stoffen en geneesmiddelen zijn dierproeven nu nog in de wet verplicht. Volgens het NCad kunnen nieuwe technieken dierproeven op termijn vervangen. Zoals cellen-op-een-chip die bijvoorbeeld een lever nabootsen. Of computermodellen die de werking van bepaalde stoffen kunnen voorspellen.
Nederland koploper
Nederland kan in 2025 internationaal koploper zijn op het gebied van proefdiervrije vernieuwingen. Volgens het NCad kan dat onder meer door:
- proefdieren terug te dringen in het biomedisch en veterinair onderwijs;
- onderwijs en training in alternatieve methoden voor wetenschappers;
- vervangen dierproeven door onderzoek met bijvoorbeeld menselijk (cel)materiaal.
Volgens het NCad moet de Rijksoverheid de regie nemen om dit voor elkaar te krijgen.
Lees verder in het advies Transitie naar proefdiervrij onderzoek (december 2016) van het NCad.
Nederland moet in 2025 wereldleider zijn in het versnellen van de transitie naar onderzoeksmethoden zonder proefdieren. Dat stelt staatssecretaris Martijn van Dam (Economische Zaken) in een brief aan de Tweede Kamer.
Alternatieven voor dierproeven
De Rijksoverheid stimuleert ontwikkeling van alternatieven voor dierproeven. Bijvoorbeeld met:
- stappenplan RIVM: met concrete doelen om het aantal proefdieren te verminderen;
- netwerk Pioniers Proefdiervrije Innovatie: topwetenschappers, innovatieve bedrijven en maatschappelijke organisaties wisselen hier kennis uit over alternatieven voor dierproeven.
Lees verder in de Kamerbrief Dierproeven (15 december 2016).
De Nederlandse overheid moet flinke stappen zetten om ons land koploper te laten worden in proefdiervrije innoveren. Dit is een van de conclusies van een rondetafelgesprek van belanghebbenden met de Tweede Kamer.
Proefdiervrij innoveren
Diverse partijen informeren de Kamer over (on)mogelijkheden van proefdiervrij innoveren. De gesprekken zijn verdeeld in 4 blokken:
- Over het belang van proefdiervrije methoden en de stand rond proefdiervrije technologieën. Zoals computersimulaties of het gebruik van menselijk weefsel.
- Hoe non-gouvernementele organisaties (NGO’s) samenwerken en bijdragen aan de overgang naar proefdiervrij onderzoek.
- Adviezen over de ontwikkeling van proefdiervrije vernieuwingen en hoe die ingevoerd kunnen worden.
- Het nut van dierproeven bij het beperken van gezondheidsrisico’s. En hoe deze proeven eventueel vervangen kunnen worden.
Lees verder in de position papers voor het rondetafelgesprek Ontwikkeling van proefdiervrije onderzoeksmethoden (14 september 2017).
Zonder dierproeven bepalen of chemische stoffen en geneesmiddelen veilig zijn voor de mens. Daarvoor maakte onderzoeksinstelling RIVM een agenda voor hun werk voor de Rijksoverheid.
Veiligheid beoordelen zonder proefdieren
Daarvoor is nodig volgens het RIVM:
- bewustwording: bijvoorbeeld over wanneer een stof veilig is en hoe dat getest kan worden zonder dierproeven;
- wetten en regels die proefdiervrije veiligheidsbeoordelingen toegestaan;
- veiligheidsbeoordelingen die gebaseerd zijn op de biologie van de mens of het doeldier;
- overzicht van proefdiervrije innovaties: zoals computermodellen, celkweken en het meten van stoffen in urine, bloed of haar (biomonitoring).
- informatieportaal en netwerkorganisaties: voor het ontwikkelen en uitvoeren van proefdiervrije innovaties op regionale, nationale en internationale niveaus.
Lees verder in de Agenda proefdiervrije innovaties in het regulatoire veld (PIRV) (maart 2018).
De Rijksoverheid wil proefdiervrije innovatie versnellen. Verschillende overheden, wetenschappelijke en maatschappelijke organisaties werken daarvoor samen in het partnerprogramma TPI. De partners hebben als ambitie: Nederland voorloper in de internationale transitie.
Netwerken voor nieuwe ideeën
TPI vraagt wetenschappers en andere deskundigen in vernieuwingsnetwerken ideeën te bedenken en uit te proberen voor proefdiervrije innovaties. Zoals:
- regels maken voor de veiligheid van proefdiervrije methoden;
- behoeften van bedrijven bespreken: welke uitdagingen hebben zij bij het vermarkten van hun proefdiervrije innovaties;
- begrijpelijker maken van (het belang van) proefdiervrije innovatie voor het publiek.
Lees verder over de Transitie Proefdiervrije Innovatie, Filosofie en werkwijze (4 juni 2018).
Redenen TPI
Enkele redenen die de overheid noemt voor het partnerprogramma:
- ethische- en maatschappelijke zorgen over het welzijn van proefdieren;
- beperkte voorspellende waarde van dierproeven;
- kansen proefdiervrije innovaties: zoals geneesmiddelen sneller en goedkoper op de markt brengen.
Lees verder in de Kamerbrief Transitie Proefdiervrije Innovatie (TPI) (1 juni 2018).
Hoe kunnen proefdiervrije methoden helpen om aandoeningen te bestrijden bij de mens? Dat is de centrale vraag bij de eerste TPI-Helpathon in november 2018 bij de Nederlandse Brandwonden Stichting.
Brandwond in reageerbuis
Hoe kunnen brandwonden en de doorbloeding van het gebied rond de wond worden onderzocht zonder proefdieren? Onderzoekers van brandwonden, Amsterdam UMC, zorgprofessionals en geneesmiddelenbedrijf Pharming bedachten een oplossing. Daarbij worden in een reageerbuis brandwonden nagebootst op menselijke huid en onderzocht.
Creatieve oplossingen
Bij een helpathon bedenken teams creatieve oplossingen voor één centrale vraag van iemand die proefdiervrij wil gaan onderzoeken. De bijeenkomsten zijn afgeleid van ‘hackathons’ om in een korte tijd software of hardware te maken.
Lees meer over de resultaten van deze eerste en andere Helpathons
Ruim 100 professionals agenderen en bespreken ideeën voor het stimuleren of beoordelen van onderzoeks- en testmethoden zonder proefdieren. Dat is de opzet van de eerste brede netwerkbijeenkomst over de Transitie Proefdiervrije Innovatie (TPI) op 11 maart 2019 in het LUMC in Leiden.
Creatieve oplossingen
Er zijn vertegenwoordigers uit de hele keten. Zoals wetenschappers, beleidsmakers, financiers van onderzoek, vertegenwoordigers van bedrijven en maatschappelijke organisaties. Ze ontmoeten elkaar in een zogeheten ‘open space’. Dit is een gespreksvorm waarbij iedere deelnemer gesprekspunten kan agenderen en inzichten kan delen. Door de spontaniteit en toeval ontstaan vaak creatieve oplossingen of nieuwe samenwerkingsverbanden. Net zoals in de koffiepauze vaak gebeurt.
Biomedische wetenschappers van de kenniscentra in Amsterdam, waaronder Amsterdam UMC, Vrije Universiteit Amsterdam, Universiteit van Amsterdam en Academisch Centrum Tandheelkunde (ACTA) komen bijeen om te bespreken wat er in Amsterdam al gebeurt op het gebied van proefdiervrije innovaties en om een “Plan van Aanpak” te maken.
Themagroepen
Actiepunten worden onderverdeeld in themagroepen zoals Onderwijs, Symposia en Netwerken, Organoïde modellen, Transparantie in Dieronderzoek in Amsterdam, Fondsenwerving en Maatschappelijke Impact.
2024: Amsterdam 4Rs Centrum
In februari 2024 wordt TPI Amsterdam onderdeel van het nieuwe Amsterdam 4Rs Centre. Doel is om bij te dragen aan de transitie naar proefdiervrij onderzoek door kwalitatief hoogwaardig onderzoek uit te voeren met aandacht voor 4Rs (Reduction, Replacement, Refinement of animal experiments and Reproducibility of animal free methods).
Lees meer over het Amsterdam 4Rs centrum en Amsterdam TPI
Hersenonderzoek kan voorlopig niet zonder dierproeven. Dat concludeert de KNAW op basis van een inventarisatie onder haar leden.
Mix van methoden en technieken
In de inventarisatie komen ook vernieuwende methoden voor neurowetenschappelijk onderzoek aan bod. De KNAW concludeert dat proefdiervrije methoden en technieken zich de komende 10 jaar verder kunnen ontwikkelen. Maar proefdiervrij onderzoek kan op zichzelf onvoldoende antwoord geven op de belangrijkste onderzoeksvragen. Daarvoor blijft onderzoek nodig met een mix van methoden en technieken.
Lees verder over de publicaties van de KNAW in:
In 2040 leven alle Nederlanders tenminste 5 jaar langer in goede gezondheid. Daarvoor stimuleert de Rijksoverheid onder meer innovaties in de topsector Life Science & Health.
Onderzoek chronische ziekten
Daarvoor is ook onderzoek naar chronische ziekten en dementie van belang. Een geneesmiddel tegen dementie is er nog niet. Onderzoek met proefdieren blijkt geen goede voorspeller te zijn voor een succesvolle behandeling bij mensen. Daarom is onderzoek op basis van andere technieken, zoals met cellen of weefsel van mensen (humane meetmodellen) belangrijk.
Lees verder over de gezondheidsdoelen van de overheid in het Kennis- en Innovatieconvenant 2020-2023 (KIC) (15 november 2019).
In 5 tot 10 jaar zo veel mogelijk dierproeven vervangen door onderzoek zonder dieren. Dat kan met het stappenplan van het Nationaal Comité advies dierproevenbeleid (NCad). Daarmee maken onderzoekers voor hun terrein een ‘streefbeeld’ waarin staat hoe ze dat aanpakken en wat op basis van de huidige kennis haalbaar is.
Overleg belanghebbenden
Bij het opstellen van een streefbeeld overleggen wetenschappers met andere belanghebbenden. Zoals:
- patiëntenorganisaties
- dierenbelangenorganisaties
- transitiedeskundigen
Streefbeeld opstellen
In het streefbeeld staat onder meer:
- doel en wanneer dit wordt bereikt;
- welke proefdiervrije methodes worden gebruikt;
- hoe kansrijk die methodes zijn;
- aanpak en start van het project.
Lees verder over streefbeelden voor proefdiervrij onderzoek bij het NCad.
Wat is proefdiervrij innoveren en hoe doe je dat? Een Engelstalige gids met voorbeelden van 26 bedrijven laat zien hoe dat werkt in de praktijk.
De gids bevat ook artikelen over de context waarin beginnende bedrijven (start-ups) opereren in Nederland. Samenwerking van start-ups met grotere bedrijven blijkt daarin essentieel voor het ontwikkelen van proefdiervrije alternatieven.
Lees verder in de gids TPI booklet: 26x better and faster without the use of animals (22 november 2019).
150 professionals uit 16 landen zijn van 27 tot en met 29 november 2019 in Utrecht voor de internationale TPI-conferentie. Allemaal hebben ze één doel voor ogen: het uitwisselen van kennis en ervaringen om proefdiervrije innovatie te versnellen. De TPI-partners laten zien hoe Nederland versnelling van de transitie aanpakt.
Prijs voor proefdiervrij testen
Tijdens de conferentie krijgt Remco Westerink de Willy van Heumenprijs 2019. Hij is hoofd van de onderzoeksgroep Neurotoxicologie van de Universiteit Utrecht. De prijs krijgt hij voor het ontwikkelen van proefdiervrije testen met hersencellen van mensen die hij kweekt op printplaten.
Lees verder in de Terugblik conferentie Transitie naar proefdiervrije Innovatie (TPI) (29 januari 2020).
Wetenschappers in het Utrecht Science Park werken met elkaar samen om de overgang naar proefdiervrije innovatie te versnellen. Dit gebeurt in het lokale netwerk TPI Utrecht met toponderzoekers uit biomedische en innovatiewetenschappen.
Helpdesk
De lokale werkgroep helpt onderzoekers en docenten. Bijvoorbeeld met een helpdesk om in contact te komen met experts in dierproefvrij onderzoek. Ook worden er zogeheten helpathons gehouden. Daarbij bedenken teams creatieve oplossingen voor één centraal probleem.
TPI Utrecht
Het lokale TOI-netwerk heet TPI Utrecht en werkt samen met het programma Transitie Proefdiervrije Innovatie van de Rijksoverheid.
Lees verder over TPI Utrecht op de Engelstalige webpagina Transition to Animal-free Innovations.
Heb je als professional hulp nodig bij proefdiervrij onderzoek? Of wil je juist kennis delen over proefdiervrije innovatie? Dan kun je terecht op TPI.tv.
Video’s voor en door professionals
Op TPI.tv kunnen professionals video’s plaatsen. Daarin kunnen ze collega’s wereldwijd inschakelen die oplossingen zoeken voor onderzoek zonder proefdieren. Bijvoorbeeld:
- wetenschappers: ook uit andere domeinen;
- beoordelaars van veiligheid;
- bedrijven die werken aan proefdiervrije modellen en testen.
Lees verder over het online-uitwisselingsnetwerk TPI.tv.
Beter voorspellend gezondheidsonderzoek dat minder afhankelijk is van dierproeven. Dat is het doel van het onderzoeksprogramma Humane Meetmodellen. Voor het programma is in totaal ruim € 16 miljoen beschikbaar gesteld door onderzoeksfinanciers en TPI-partners.
Beter onderzoek zegt meer over mensen
Onderzoek met menselijke cellen, weefsels of computermodellen die zijn gebaseerd op menselijke data, benaderen de situatie in de mens beter dan dierproeven. Daarom ondersteunt dit programma alternatieven voor dierproeven. Zoals:
- oog-op-een-chip: met gekweekte netvliescellen van patiënten oogziekten beter begrijpen en behandelingen testen.
- computermodellen: om hersenziekten beter in beeld te krijgen;
- meetmethode die de communicatie tussen hersenen en organen zoals de blaas in beeld brengt om incontinentie te voorkomen.
Lees verder:
- Humane Meetmodellen, Samenwerkende Gezondheidsfondsen (SGF);
- Programma Humane Meetmodellen 2.0, NWO.
Er zijn veel technologische innovaties om dierproeven te vervangen. Maar de grote omwenteling moet nog komen. Daarvoor zijn doorbraken nodig in wetten en regels, onderwijs en ethiek. Dit stelt onderzoeksinstituut DRIFT.
De overgang naar proefdiervrij onderzoek zit nu in de fase van voorontwikkeling. DRIFT ziet 2 mogelijke ontwikkelingen die leiden naar brede invoer en acceptatie van alternatieven:
- gepersonaliseerde gezondheidzorg: kennis over de mens wordt de basis van onderzoek voor de mens. Dit vervangt dierproeven als ‘gouden standaard’;
- veiligheidsbeoordelingen: onderzoek met mensen of menselijke cellen voorspelt beter de veiligheid van geneesmiddelen of chemische stoffen dan dierproeven. Nieuwe richtlijnen op basis van kennis over de mens zijn daarvoor nodig.
Lees verder:
- Samen kansrijke transitiepaden inslaan naar proefdiervrije innovatie (2 juli 2020);
- Interview met Jan Rotmans van Dutch Research Institute For Transitions.
Extra geld voor proefdiervrij onderzoek naar effecten van het coronavirus. Dat stellen onderzoeksfinancier ZonMw en Stichting Proefdiervrij beschikbaar.
5 corona-onderzoeken
Het geld gaat naar 5 corona-onderzoeken:
- Amsterdam UMC: werkt inhaleren van heparine preventief tegen bloedstolsels? Dan kan bijvoorbeeld zorgpersoneel zich hiermee beschermen bij besmetting.
- Sophia Kinderziekenhuis: kweekt cellen van menselijke luchtwegen en bloedvaten om het ontstaan en verloop van virusinfecties, zoals COVID-19 te bestuderen.
- UMC Utrecht: bestudeert met cellen van donoren wat het effect is van corona op de neus, longen, darmen en nieren.
- Universiteit Twente: bestudeert bloedstollingen door bloedplasma van patiënten te gebruiken in een model van minibloedvaten op een microchip.
- LUMC: onderzoekt hoe menselijke epitheelcellen reageren op het virus en hoe die reactie longschade veroorzaakt.
Lees verder:
Nederland is internationaal voorloper in het stimuleren van proefdiervrije innovatie. Dat staat in de zelfevaluatie van het programma Transitie naar Proefdiervrije Innovatie (TPI).
Rijksoverheid regisseur overgang dierproefvrij
Vernieuwend is vooral dat de Rijksoverheid regisseur is van de transitie. Voor de versnelling en overgang naar proefdiervrij onderzoek zijn partners uit de hele keten onmisbaar. De Nederlandse aanpak met het partnerprogramma TPI trekt inmiddels ook de aandacht van buitenlandse wetenschappers en instanties.
3 keer vooruitgang
De vooruitgang in het proces naar dierproefvrij innoveren is op 3 manieren gemeten:
- groeiende netwerk: meer wetenschappers, beleidsmakers en bedrijven delen kennis over dierproefvrije methoden en technieken;
- anders kijken naar onderzoeksvoorstellen: voor proefdieronderzoek is minder vanzelfsprekend;
- visie over alternatieven voor dierproeven: deze voorspellen vaak beter de effecten in de mens van bijvoorbeeld medicijnen en chemische stoffen.
Lees verder:
Een heffing van 1% op het onderzoeksbudget voor dierproeven levert te weinig effect op voor onderzoek zonder dierproeven. Flink hogere investeringen in alternatieven zorgt wel voor een daling van het aantal dierproeven. Dat blijkt uit onderzoek van adviesbureau Technopolis Group.
Slechter wetenschapsklimaat
Een heffing op dierproeven leidt ook tot een slechter wetenschapsklimaat. Mogelijk verschuift daardoor ook onderzoek naar het buitenland. Het adviesbureau verwacht dat daardoor ook het draagvlak voor de overgang naar dierproefvrije onderzoeksmethoden vermindert.
Lees verder in de Studie naar de financiën van proefdieronderzoek en dierproefvrije innovaties (13 november 2020).
Digitale 3D-dieren voor anatomielessen in plaats van echte dieren. Dat was de winnende inzending voor de 1e Proefdiervrij Venture Challenge. Winnaar Avatar Zoo krijgt € 25.000 om hun virtual reality-modellen verder te brengen.
Impact proefdiervrij onderzoek
Met de challenge wil Stichting Proefdiervrij de impact van proefdiervrij onderzoek vergroten en versnellen. Het is een programma van 10 tot 12 weken waarin een proefdiervrije wetenschappelijke doorbraak wordt omgezet in een bedrijfsplan. Teams van onderzoekers krijgen daarbij begeleiding om hun idee om te zetten in een succesvolle onderneming.
Lees verder over de Proefdiervrij Venture Challenge op de website van proefdiervrij.nl.
Medicijnen en chemische stoffen testen met computerprogramma’s met gegevens over de biologie van de mens. Dat is de opzet van onderzoeksproject 'Virtual Human Platform for safety assessment' (VHP4Safety). Dit kan in de toekomst dierproeven binnen de huidige veiligheidsbeoordelingen vervangen.
Effect medicijn voorspellen
Onderzoekers werken aan een computermodel, ‘virtuele mens’, die kan voorspellen wat het effect is van een ingebrachte stof in het lichaam. Daarmee kunnen bijvoorbeeld bijwerkingen van medicijnen beter en sneller ontdekt worden. In VHP4Safety werken deskundigen samen vanuit de datawetenschap, toxicologie, (bio)technologie en transitiekunde.
Lees verder in het document Op naar een betrouwbare veiligheidsbeoordeling met proefdiervrije innovaties (28 juli 2021).
Hoe zorgen we ervoor dat bestaande proefdiervrije modellen ook echt gebruikt mogen worden? Wetenschapsfinancier NWO stelt bijna € 3 miljoen beschikbaar voor onderzoek dat die vraag beantwoordt.
Veiligheid stoffen
Mensen worden elke dag blootgesteld aan chemische stoffen in geneesmiddelen, cosmetica en het milieu. Om de mens te beschermen is het nodig de veiligheid van die stoffen te beoordelen. Het vertrouwen moet nog groeien dat dit op termijn ook kan met proefdiervrije modellen, gebaseerd op kennis en data over de mens.
Probleem oplossen
Door een gebrek aan bewustzijn en vertrouwen blijft acceptatie en het gebruik van bestaande proefdiervrije modellen achter. NWO vraagt daarom wetenschappers, regelgevers en bedrijfsleven samen met voorstellen te komen om oplossingen voor dit probleem te onderzoeken.
Lees verder over het thematische NWA-programma Proefdiervrije modellen: acceptatie en implementatie
Het kabinet wil doorgaan met het programma voor versnelling van de Transitie Proefdiervrije Innovatie (TPI). Ook wil het de overgang naar proefdiervrij onderzoek beter bespreekbaar maken. Bijvoorbeeld door verhalen te delen over mogelijkheden die alternatieven bieden. En door in gesprek te blijven met partijen met verschillende meningen.
Versnellen overgang proefdiervrij onderzoek
In deze fase van TPI moeten initiatieven van alle betrokkenen de overgang naar proefdiervrij onderzoek gericht versnellen. Het kabinet wil de versnelling van de transitie monitoren en ervoor zorgen dat partijen die verschillend denken, met elkaar in gesprek blijven over het onderwerp.
Lees verder in de Kamerbrief over het vervolg in 2021-2023 van het programma Transitie Proefdiervrije Innovatie (TPI) (21 juli 2021).
Het Europees Parlement wil laboratoriumproeven met dieren sneller afschaffen. De parlementariërs vragen daarvoor een plan van de Europese Commissie (EC), het dagelijks bestuur van de Europese Unie (EU).
Actieplan voor oplossen knelpunten
In de EU zijn onderzoekers al verplicht om niet-dierlijke testmodellen te gebruiken wanneer die beschikbaar zijn. Het parlement wil dat er een actieplan van de EC komt om knelpunten op te lossen rond het gebruik van alternatieven voor dierproeven. Dit actieplan moet zich richten op onderzoek, voorgeschreven proeven voor de veiligheidsbeoordeling en onderwijs. Het parlement wil uiteindelijk dierproeven helemaal afschaffen.
Lees verder in de Resolutie om de overgang naar innovatie te versnellen zonder proefdieren (16 september 2021) van het Europees Parlement.
Systematisch vergelijken van bestaand onderzoek (systematic review) kan de kwaliteit van proefdieronderzoek verbeteren. Dit blijkt uit een studie van ZonMw naar 8 jaar financiering voor systematic reviews.
Betere kwaliteit onderzoek
Zonder literatuuronderzoek blijken onderzoekers geregeld een verkeerd diermodel te gebruiken. Bijvoorbeeld een verkeerde stam ratten. Literatuuronderzoek verbetert de kwaliteit van de opzet, uitvoering en rapportage van onderzoek.
Bewuster over gevolgen onderzoek
Ook blijken onderzoekers na een literatuuranalyse bewuster van de gevolgen van proefdieronderzoek en proefdiervrije innovaties. Zo rapporteren ze beter over:
- huisvesting van de dieren;
- gekozen behandeling;
- rechtvaardiging van het diermodel.
Literatuuronderzoek voorkomt daarmee onnodig gebruik van proefdieren (animal waste) en overbodige herhaling van onderzoek (research waste).
Lees verder:
- artikel Systematisch literatuuronderzoek vervangt, vermindert en verfijnt proefdieronderzoek (10 november 2020), ZonMw;
- Engelstalig artikel The impact of conducting preclinical systematic reviews on researchers and their research: A mixed method case study (13 december 201), PLOS ONE.
Kennis delen en bijdragen leveren aan proefdiervrije innovaties. Dat is het doel van Young TPI, een netwerk voor studenten en jonge professionals tot 35 jaar.
Proefdiervrije start carrière
Jonge mensen hebben de mogelijkheid om hun carrière proefdiervrij te beginnen. Young TPI wil hen daarom in een vroeg stadium informeren over alle mogelijkheden. Ook delen ze in het netwerk hun eigen ervaringen. Zodat bijvoorbeeld vernieuwende ideeën over proefdiervrije modellen voor onderzoek zich verder kunnen verspreiden.
Doelen Young TPI
- bijdragen aan versnellen transitie proefdiervrije innovatie;
- bewustzijn creëren, kennis delen over bestaande innovaties;
- helpen bij carrièreperspectieven: bijvoorbeeld door contact te leggen met werkgevers en het ontwikkelen van professionele vaardigheden;
- adviseren en communiceren over proefdiervrije innovaties.
De BATI laat zien wat kennisinstellingen doen op het gebied van proefdiervrije innovatie en de 3Vs: vervangen, verminderen en verfijnen van dierproeven.
Vorderingen vergelijken
Met de BATI kunnen kennisinstellingen hun inspanningen op het terrein van proefdiervrije innovatie onderling vergelijken en zo nieuwe inzichten opdoen.
Voordelen BATI
- benchmark: vergelijkt prestaties en beleid proefdiervrij onderzoek in Nederland;
- monitoring: laat zien hoe de overgang verloopt naar proefdiervrije innovatie;
- 'best practices': laat goede voorbeelden zien waar anderen van kunnen leren;
- stimuleert transparantie en samenwerking voor proefdiervrije innovatie;
- levert wetenschappelijk bewijs (evidence based) voor ontwikkelen van beleid.
Lees verder op de website van BATI.
Het Europees Partnerschap voor de risicobeoordeling van chemische stoffen (PARC), gaat in mei 2022 in Parijs (Frankrijk) van start. PARC ontwikkelt een chemische risicobeoordeling van de volgende generatie, waarbij zowel de menselijke gezondheid als het milieu in een "One Health"-aanpak worden meegenomen.
Het partnerschap levert een bijdrage aan de ondersteuning van de EU-strategie voor duurzame chemische stoffen en het streven van de European Green Deal naar "zero pollution". Bijna 200 partners uit 28 landen en EU-agentschappen nemen deel. Dit Europese initiatief wordt gecoördineerd door ANSES en gefinancierd door het kaderprogramma voor onderzoek en innovatie Horizon Europe van de Europese Commissie en door de deelnemers aan het partnerschap.
Het partnerschap bouwt voort op eerdere werkzaamheden, met name de acties die zijn ondernomen in het kader van het Europees gezamenlijk programma HBM4EU (Human Biomonitoring for Europe) en op eerdere werkzaamheden van verschillende Europese projecten en programma's, zoals de EURION- en ASPIS-clusters, EU-ToxRisk en EuroMix. https://www.eu-parc.eu/
Op 29 december 2022 ondertekent president Biden de FDA Modernization Act 2.0. Het wetsvoorstel vervangt de Federal Food, Drug, and Cosmetics Act van 1938, die dierproeven verplicht stelde voor elk nieuw protocol voor de ontwikkeling van medicijnen.
De nieuwe wet wijzigt de Federal Food, Drug, and Cosmetic Act door bedrijven en onderzoekers die nieuwe medicijnen ontwikkelen, toe te staan om gebruik te maken van "bepaalde alternatieven voor dierproeven, waaronder celgebaseerde testen en computermodellen om de veiligheid en effectiviteit van een medicijn te onderzoeken".
De nieuwe wet "schrapt ook de eis om dierproeven te gebruiken als onderdeel van het proces om een licentie te verkrijgen voor een biologisch product dat biosimilair of uitwisselbaar is met een ander biologisch product".
Link: FDA Modernization act 2.0 (Engels)
Honderden dierenwelzijnsorganisaties en cosmeticamerken lanceren in januari 2023 het Europees burgerinitiatief (ECI) "Red proefdiervrije cosmetica - Zet je in voor een Europa zonder dierproeven".
Ruim 1,2 miljoen Europese burgers tekenden deze petitie tegen het gebruik van dierproeven voor cosmetica. De Europese cosmeticawet die in 2013 in werking trad en die testen van cosmetica op dieren verbiedt, blijkt namelijk toe te laten dat bepaalde ingrediënten tóch op proefdieren getest mogen worden om zo de veiligheid van medewerkers in het productieproces te garanderen. Het initiatief pleit voor versterking van het verbod op dierproeven voor cosmetica, het transformeren van de chemische regelgeving en het moderniseren van de wetenschap door middel van wetgevingswijzigingen die:
- Garanderen dat geen van de cosmetica-ingrediënten voor geen enkel doel en op geen enkel moment worden getest op dieren
- Geen nieuwe dierproeven eisen in het kader van de chemicaliën wetgeving
- Toewerken naar een stappenplan voor volledige uitfasering van dierproeven
De Europese Commissie heeft een mededeling gepubliceerd naar aanleiding van dit burgerinitiatief. De Commissie geeft hierin onder andere aan dat het verbod op dierproeven voor cosmetica onverminderd van kracht blijft, maar dat er ook gevallen zijn waar dierproeven nog nodig zijn. Ook wordt er een stappenplan voor het uitfaseren van dierproeven voor veiligheidstests voor chemische stoffen opgezet, in samenwerking met stakeholders, experts en lidstaten.
Young TPI (Transitie Proefdiervrije Innovatie) wordt in 2023 een zelfstandige stichting. Het begon als een spin-off van het overheidsprogramma TPI. Young TPI is een groep enthousiaste en gemotiveerde jonge professionals, PhDs en studenten van verschillende achtergronden. Ze delen een interesse in de transitie naar proefdiervrije innovaties en willen bijdragen aan de versnelling van de transitie.
Het bestuur bestaat uit studenten en jonge onderzoekers die zich met hart en ziel inzetten om proefdiervrije innovaties verder te brengen. Ze organiseren netwerkbijeenkomsten en dragen bij aan wetenschappelijk onderwijs (onder andere). Link naar website Young TPI (lancering medio 2024)
Het Nationaal Comité advies dierproevenbeleid (NCad) publiceert begin 2023 ongevraagd een advies over mogelijkheden om menselijk weefsel te gebruiken voor onderzoek in plaats van dierproeven.
Het belang van menselijk weefsel voor onderzoek en onderwijs is groot. Het gebruik van menselijk weefsel kan zorgen voor vervanging van dierproeven. Daarom stelt het NCad de vraag: In hoeverre is menselijk weefsel beschikbaar voor wetenschappelijk onderzoek en onderwijs? En hoe kunnen beschikbaarheid en gebruik worden gestimuleerd en vereenvoudigd, ter vervanging van of complementair aan proefdieren?
ZonMw-voorzitter Arfan Ikram overhandigt op 13 april de ZonMw Kennisagenda Transitie naar Proefdiervrije Innovaties aan minister Adema van Landbouw, Natuur en Voedselkwaliteit. Met deze kennisagenda wil ZonMw de discussie in het veld stimuleren. De kennisagenda is ook de basis voor een ambitieus, langjarig kennis- en innovatieprogramma om zo in de toekomst meer waardevol humaan-relevant onderzoek met zo min mogelijk dierproeven mogelijk te maken.
ZonMw ontwikkelde de Kennisagenda op grond van gesprekken met bijna 60 onderzoekers, ondernemers, regelgevers, brugfiguren, financiers, studenten en docenten van verschillende Nederlandse universiteiten en instellingen. Uit deze inventarisatie komen kansen, obstakels en kennisvragen naar voren. Er zijn acht aanbevelingen gedaan. Zo blijkt dat er veel gewerkt moet worden aan de validatie van proefdiervrije modellen, om de wetenschappelijke waarde en geschiktheid aan te tonen, en daarmee het gebruik te stimuleren. Ook is het nodig om innovaties te ontwikkelen waarmee onderzoekers complexere vragen kunnen beantwoorden. In de opleiding van onderzoekers zou proefdiervrij onderzoek centraal moeten staan, en wordt het belang van interdisciplinaire samenwerking benadrukt.
Kennisagenda Transitie naar Proefdiervrije Innovaties | ZonMw
In mei vindt de hoorzitting van de Committee on Environment, Public Health and Food Safety (ENVI) van het Europees Parlement Home plaats over het Europees burgerinitiatief (ECI) "Red proefdiervrije cosmetica - Zet je in voor een Europa zonder dierproeven".
In aanloop daar naartoe publiceren verschillende Europese onderzoeksfinanciers een gezamenlijke verklaring: ‘Human and animal health, preservation of species and biodiversity, require the use of animals and of non-animal approaches in science’. De Franse National Alliance for Life Sciences and Health (AVIESAN) en de Nederlandse Organisatie voor Gezondheidsonderzoek en Zorginnovatie (ZonMw) roepen daarin beleidsmakers in Europa op om essentiële inzichten uit de biomedische wetenschappen mee te nemen in de politieke discussies over het gebruik van dieren voor wetenschappelijk onderzoek. Deze verklaring wordt ondersteund door vele andere Europese onderzoeksfinanciers en -organisaties.
Voor het gebied cardiovasculair onderzoek ontwikkelt het NCad samen met de Dutch CardioVascular Alliance (DCVA) een streefbeeld voor cardiovasculair onderzoek. Het belangrijkste doel van dit streefbeeld is toepassen van experimentele modellen. Deze modellen hebben een voorspellende waarde voor de cardiovasculaire patiënt. En de modellen kunnen de onderzoeksvragen op een zo goed mogelijke manier beantwoorden.
Er is voor gekozen om dit streefbeeld vanuit de Dutch CardioVascular Alliance te organiseren, een samenwerkingsverband van 22 partners. Dit zijn organisaties die in onderzoek investeren, medische en technische onderzoekers, gebruikers en patiënten. In het streefbeeld staan 7 adviezen. In de bijlage staan concrete voorstellen die diermodellen door humane meetmodellen kunnen vervangen. Hierbij worden ook de beperkingen van beide soorten modellen vermeld. Adviesrapport streefbeeld cardiovasculair onderzoek | Rapport | Nationaal Comité advies dierproevenbeleid (ncadierproevenbeleid.nl)
Streefbeelden proefdiervrij onderzoek zijn doelen waar een vakgebied naar toe wil zonder dierproeven te gebruiken. Het NCad introduceert een concept voor dit streefbeeld in een transitieadvies: bouw dierproeven af en stimuleer innovaties zonder dieren. Hiermee kunnen verschillende wetenschapsvelden een eigen streefbeeld ontwikkelen. Het NCad adviseert hierin en houdt de ontwikkelingen rond proefdiervrij onderzoek nauw in de gaten
De Europese Commissie reageert op 25 juli op het burgerinitiatief ’Save cruelty-free cosmetics – committing to a Europe without animal testing’. In de reactie van de Europese Commissie is aandacht voor de initiatieven die de transitie naar proefdiervrije innovaties zullen versnellen. De aanbevelingen zijn in lijn met het Nederlandse TPI-beleid.
De Europese Commissie onderstreept dat het uitfaseren van dierproeven pas kan wanneer dat wetenschappelijk verantwoord is en er voldoende goede alternatieven zijn. De focus van de toezeggingen van de Europese Commissie ligt op het ontwikkelen, valideren en toepassen van proefdiervrije methoden die dierproeven kunnen verminderen en vervangen.
In de reactie kondigt de Europese Commissie een stappenplan voor de afbouw dierproeven bij wettelijk vereiste veiligheidstests van chemische stoffen, die gezamenlijk met stakeholders en lidstaten opgezet zal worden.
De Europese Commissie heeft ook in grote lijnen de verklaring onderstreept die door veel internationale onderzoeksfinanciers en -organisaties is ondertekend en door ZonMw en het Franse AVIESAN is opgesteld.
Commission acts to accelerate phasing out of animal testing (europa.eu)
In augustus 2023 vindt het 12th World Congress on Alternatives and Animal Use in the Life Sciences, in Niagara Falls in Canada. Het thema is REPLACE. REDUCE. REFINE. 3RS OVER THE EDGE. Nederland is één van de best vertegenwoordigde landen, niet alleen vanwege het aantal deelnemers maar ook met 28 presentaties en 29 posters.
De Nederlandse inbreng (van TPI-partners en anderen) gaat bijvoorbeeld over de TPI-aanpak in Nederland, de Venture Challenge, de impact van onderzoekfinanciers, VHP4Safety, onderwijs, Helpathons, BATI, Young TPI, streefbeelden en preregistratie van dierproeven. Ook is er veel aandacht voor het European citizens initiative (ECI) en de reactie van de Europese Commissie daarop.
Het Wereldcongres werd in 1993 opgericht door de Alternatives Congress Trust in Baltimore (VS) om multidisciplinaire belanghebbenden en belangstellenden uit de academische wereld, de industrie, de overheid en de non-profitsector onder één dak samen te brengen om de 3 V's te bevorderen: het gebruik van dieren in de biowetenschappen verminderen, verfijnen en vervangen. Sinds 1993 is de WC-serie twee- of driejaarlijks gehouden op verschillende continenten, van Noord- en Zuid-Amerika tot Europa en het Verre Oosten.
Het NCad brengt in augustus 2023 een nieuwe zienswijze. Daarin bespreekt het NCad de overwegingen om sommige dierproeven te prioriteren voor het zoeken naar of ontwikkelen van een dierproefvrij alternatief.
Het Nationaal Comité advies dierproevenbeleid (NCad) stelde zich in 2021 de vraag of het mogelijk is te prioriteren welke dierproeven als eerste zouden moeten worden vervangen door NAMs (New Appraoch Methodologies). Hierbij werd onder andere gedacht aan diermodellen met een beperkte translationele waarde waar translatie van onderzoeksresultaten wèl van belang is, diermodellen die ernstig ongerief met zich meebrengen en diermodellen met een weinig relevant of ethisch discutabel doel.
Het NCad ontwikkelt deze zienswijze met criteria die behulpzaam zijn bij het stellen van prioriteiten bij het vervangen en uitfaseren van diermodellen. De basis hiervoor is een rapport over prioriteren van dierproeven voor vervanging, dat wil zeggen over de criteria waarmee beoordeeld kan worden voor welke diermodellen met voorrang NAMs zouden moeten worden gezocht.
In oktober 2023 is het project VitalTissue gehonoreerd om een nieuwe infrastructuur in te richten waarmee vitaal menselijk restweefsel beschikbaar en bruikbaar wordt gemaakt voor gezondheidsonderzoek. De komende jaren financieren ZonMw, de ministeries van Landbouw, Natuur en Voedselkwaliteit, Volksgezondheid Welzijn en Sport, Onderwijs Cultuur en Wetenschap, Stichting Proefdiervrij en ETB-BISLIFE deze nieuwe infrastructuur VitalTissue.
Met deze subsidie kan de Nederlandse weefselbank ETB-BISLIFE VitalTissue in haar organisatie implementeren. Daarmee kunnen onderzoekers in de nabije toekomst restweefsel van operaties gaan gebruiken voor hun onderzoek. VitalTissue draagt hiermee bij aan resultaten die beter vertaalbaar zijn naar de mens en aan de transitie naar proefdiervrije innovaties.
LNV heeft in samenwerking met OCW, de Europese Commissie en verschillende lidstaten een voorstel voor de beleidsagenda 2025-2027 van de European Research Area (ERA) ingediend. Dit beleidsinstrument is erop gericht om onderzoeksbeleid en onderzoeksprogramma’s van Europese lidstaten op elkaar af te stemmen, zodat er betere samenwerking in de EU tot stand komt op specifieke thema’s.
Dit voorstel, waar TPI trekker van is, zet in op samenwerking en het stellen van prioriteiten tussen deelnemende landen, onder andere op het gebied van ontwikkeling en validatie van proefdiervrije innovaties, onderwijs, infrastructuur en het stimuleren van bewustzijn en transparantie. Het voorstel is nog niet formeel geaccepteerd, daarover besluiten de lidstaten later.
Het Netherlands Heart institute Preclinical Trials (PCT) ontvangt van het ministerie van LNV vervolg-financiering. Met een dergelijk register kan voorkomen worden dat al gedaan onderzoek onnodig herhaald wordt en kan de kwaliteit van onderzoek met dierproeven verbeterd en gewaarborgd worden. Dit initiatief draagt daarmee bij aan de vermindering van proefdiergebruik.
Eerder is aan het Netherlands Heart institute ook al subsidie verleend voor PCT. Deze vervolg subsidie is gericht op het duurzaam voortzetten, verbeteren en door ontwikkelen van PCT als internationaal platform. Hiermee komt het ministerie tegemoet aan de vraag uit de Tweede Kamer om individuele dierproeven te registreren.
Meer lezen over het Netherlands Heart institute Preclinical Trials (PCT).
Voor het immunologisch onderzoek ontwikkelt een werkgroep van experts op verzoek van het NCad het streefbeeld Immunologie. Dit streefbeeld wordt in december gepresenteerd. Het doel van de Immunologiewerkgroep is het ontwikkelen van een routekaart die een impuls geeft aan de transitie naar het gebruik van NAM’s binnen de immunologie.
Streefbeelden proefdiervrij onderzoek zijn doelen waar een vakgebied naar toe wil zonder dierproeven te gebruiken. Het concept voor dit streefbeeld is door het NCad geïntroduceerd in een transitieadvies: bouw dierproeven af en stimuleer innovaties zonder dieren. Hiermee kunnen verschillende wetenschapsvelden een eigen streefbeeld ontwikkelen. Het NCad adviseert hierin en houdt de ontwikkelingen rond proefdiervrij onderzoek nauw in de gaten.
Immunologie is gericht op het verkrijgen van inzicht in de moleculaire en cellulaire processen die ten grondslag liggen aan de pathologie van ziekten en infecties bij mensen. Ook richt het zich op het ontwikkelen van interventies om deze ziekten en infecties te behandelen of voorkomen. Met de diervrije methodes, of zogenaamde ‘new approach methodologies’ (NAM’s), wordt het mogelijk om immunologische processen veel gedetailleerder te onderzoeken, met meer relevantie voor ziekten en infecties bij mensen.
Het Nationaal Groeifonds investeert 124,5 miljoen euro in een nieuw landelijk Centrum voor Proefdiervrije Biomedische Translatie. Het doel van het centrum is om veiligere, effectievere en betere medische behandelingen te stimuleren met minder dieren.
Het Centrum voor Proefdiervrije Biomedische Translatie (CPBT) gaat met de bijdrage van het Nationaal Groeifonds (NGF) de transitie naar proefdiervrije biomedische innovaties versnellen. Dit zal economische en maatschappelijke winst opleveren: betere geneesmiddelen en minder dierproeven. Met een financiering voor 10 jaar biedt deze investering Nederland de kans om internationaal voorloper te worden in de transitie naar proefdiervrije innovatie, één van de ambities van het programma Transitie Proefdiervrije Innovatie (TPI).
Het CPBT gaat samen met een groot aantal nationale en internationale partijen een centrum realiseren dat de ontwikkeling en het commercieel beschikbaar maken van proefdiervrije innovaties versnelt. Het CPBT zal zich in eerste instantie gaan richten op onderzoek naar geneesmiddelen voor patiënten met ALS, taaislijmziekte, artrose/reuma of astma/COPD.
Het doel is om de ontwikkelde proefdiervrije methoden, tools en expertise samen met onderzoekers en bedrijven te implementeren. Het nieuwe centrum zal daarnaast onderwijs, trainingen, advies en ondersteuning leveren. Daarmee zal de acceptatie en gebruik van proefdiervrije biomedische innovaties versterkt worden. Uiteindelijk is het doel om deze kennis breed in te zetten, en niet alleen voor deze vier onderzoeksgebieden. Het wordt een integraal landelijk programma dat de transitie naar proefdiervrij versnelt en het verdienvermogen van Nederland versterkt.
Het Centrum voor Proefdiervrije Biomedische Translatie (CPBT) is een initiatief van de Universiteit Utrecht, het UMC Utrecht, de Hogeschool Utrecht en het Rijksinstituut voor Volksgezondheid en Milieu (RIVM).
Op 28 maart reikt de voorzitter van ZonMw, Arfan Ikram, het onderzoeksrapport “Better Science through More Transparency; Pilot study on stimulating transparent laboratory animal research” uit aan minister Robbert Dijkgraaf van OCW.
Dit onderzoeksrapport beschrijft de resultaten van een onderzoek dat ZonMw in de afgelopen 3,5 jaar, in opdracht van OCW, uitvoerde naar transparantie methodes rondom dierproeven, waarin ook concrete aanbevelingen worden gedaan aan diverse stakeholders rondom proefdieronderzoek. Op basis van dit rapport wil ZonMw in overleg treden met andere onderzoeksfinanciers over mogelijke invoering van nieuwe subsidievoorwaarden specifiek ten aanzien van transparant onderzoek met proefdieren.
Vanaf april 2024 gaat het nieuwe vierjarige ZonMw-programma Meer Kennis met Minder Dieren (MKMD) van start, wederom gefinancierd door het ministerie van LNV. Inspiratiebron voor het nieuwe programma is de ZonMw Kennisagenda ‘Transitie naar Proefdiervrije Innovaties’ en de inzichten die hiervoor opgehaald zijn.
Zo is er in het nieuwe programma veel aandacht voor de validatie van proefdiervrije technieken door middel van publiek-private samenwerkingen, om daarmee een breed gebruik ervan te stimuleren. Daarnaast wordt er op verschillende niveaus geprobeerd bij te dragen aan een verandering in de mindset rondom dierproeven. Zo worden er binnen het Off Road programma stimuleringsimpulsen verstrekt voor succesvolle aanvragen, die volledig proefdiervrij zijn. Verder worden er subsidies toegekend voor onderzoeksgroepen die het uitvoeren van een bepaalde proefdiervrije innovatie willen leren van een groep of lab met bewezen expertise op deze techniek. Daarnaast wordt er in dit programma door ZonMw gewerkt aan de ontwikkeling van de NAM Navigator, een online kennisportal die de kennis over de financiering, ontwikkeling, validatie en kwalificatie van proefdiervrije modellen op een toegankelijke wijze beschikbaar maakt voor een breed wetenschappelijk publiek.
ZonMw stimuleert al 24 jaar de ontwikkeling en toepassing van proefdiervrije innovaties.
MKMD-Programmatekst-2024-2028-vs9-Final-cover.pdf (zonmw.nl)
Het Landschap New Approach Methodologies (NAM's) voor de veiligheidsbeoordeling van farmaceutische producten biedt een actueel overzicht van de stappen die kunnen worden genomen om NAM's te implementeren in regelgevingskaders voor farmaceutische producten.
New Approach Methodologies (NAM's) kunnen dierproeven voor de veiligheidsbeoordeling van farmaceutische producten verminderen. De implementatie ervan in richtlijnen is echter complexer en er zijn veel belanghebbenden bij betrokken. De publicatie laat ook zien wie bij elke stap betrokken is. Inzicht krijgen in deze stappen is essentieel om de implementatie van NAM's te vergemakkelijken. Het landschap geeft ook voorbeelden van financierings- en onderzoeksprojecten voor NAM's. En het identificeert belangrijke trends en netwerken die van vitaal belang zijn om de acceptatie van NAM's voor het testen van de veiligheid van geneesmiddelen te vergemakkelijken.
Dit Landschap is gemaakt in samenwerking met het Regulatory Science CBG-MEB, dat gespecialiseerd is in farmaceutische producten en implementatie van NAM's. Landscape New Approach Methodologies (NAMs) for the safety assessment of pharmaceutical products | RIVM
Young TPI presenteert hun Manifesto op 18 april. Met dit manifest verklaren de leden van Young TPI hun inzet voor de transitie naar proefdiervrije innovatie. Het document bevat de principes, doelen en strategie waarmee Young TPI een toekomst wil realiseren waar innovatief onderzoek zonder proefdieren de norm is.
Aan de hand van 6 thema’s zet Young TPI de lijnen uit voor de toekomst voor jonge onderzoekers en alle belanghebbenden van de transitie naar proefdiervrije innovatie:
1. Technologies. Developing and Implementing Animal-Free Innovations
2. Transition Science. Guiding the Transition Process
3. Policy Approach. Governing the Transition
4. Education. Teaching the New Way of Thinking and Doing
5. Interdisciplinarity. Facilitating Collaboration
6. The Bigger Picture. Addressing Overarching Questions
Het manifest is geschreven met inbreng uit verschillende sessies met leden van Young TPI.
Op 19 juni kwamen meer dan 170 mensen uit de netwerken van dierproeven en proefdiervrije innovatie samen in Media Plaza van de Jaarbeurs in Utrecht. Ook sloten meer dan 70 mensen online aan. Gezamenlijk hebben de deelnemers verkend wat de toekomst kan zijn van op mensen gebaseerde biomedische en translationele wetenschap.
Er waren lezingen van Hans Clevers (Roche) en Thomas Hartung (John Hopkins) en sessies met paneldiscussies die veel vragen en inzichten opleverden over de 3V’s en NAMs (New Approach Methods). De verschillende sectoren waren goed vertegenwoordigd: onderzoekers die met NAM’s werken en 3V-onderzoekers (vervanging, vermindering en verfijning van dierproeven), deelnemers uit het regulatoire veld, beleidsmakers, ngo’s en bedrijfsleven. Zowel nationale als internationale netwerken waren vertegenwoordigd. De internationale vertegenwoordiging bestond grotendeels uit betrokkenen bij het IMP3ROVE netwerk. Er waren ook veel jonge professionals aanwezig.
De conferentie werd georganiseerd door TPI, het 3Rs Centre Utrecht, het Nationaal Comité advies dierproevenbeleid en TPI Utrecht.
Zie ook:
In september 2024 brengt het NCad een evaluatierapport uit over de implementatie van hun advies uit 2016. De conclusie is: “De transitie naar proefdiervrij onderzoek vordert zowel in Nederland als internationaal gestaag en er is beweging over alle domeinen van het wetenschappelijk onderzoek. Tegelijk blijven er nog aspecten onderbelicht die de transitie een verdere impuls kunnen geven.”
De evaluatie is uitgebracht om de voortgang van de transitie en de impact van het transitieadvies uit 2016 in kaart te brengen. In dit advies deed het NCad aanbevelingen om de transitie naar proefdiervrij onderzoek te versnellen en proefdiergebruik te verminderen.
Het rapport: Evaluatie transitie-advies 1.0
Op 25 september organiseert TPI en het Leiden Universitair Medisch Centrum (LUMC) de eerste TPI Labtour. Met deze Labtours wil TPI de ontwikkeling van proefdiervrije innovaties zichtbaar en tastbaar maken en ontmoetingen creëren met de onderzoekers die de transitie elke dag een stapje dichterbij brengen.
De deelnemers komen uit diverse sectoren: wetenschap, ngo’s, onderzoeksfinanciers en donateurs van Proefdiervrij. Ze delen dezelfde interesse: onderzoeksmodellen zonder dierproeven en de transitie naar proefdiervrije innovaties. Bij de één is de drijfveer dierenwelzijn, bij de ander beter onderzoek of een combinatie daarvan. De deelnemers bezoeken een lab met 3D-huidmodellen, 3D-hersenmodellen en het Proefdierencentrum.
Zie ook:
Hollandbio wordt per januari 2025 partner van het TPI-partnerprogramma. Met Hollandbio heeft TPI nu ook een vertegenwoordiger van de biotechnische sector aan boord en dat biedt kansen om proefdiervrije modellen sneller in de praktijk te implementeren.
In het partnerprogramma werken uiteenlopende organisaties samen om de transitie naar proefdiervrije innovatie te versnellen.
Zie ook:
- Nieuwsbericht januari 2025: TPI verwelkomt Hollandbio als partner
- Website Hollandbio
Het 3Rs Centrum Utrecht brengt in februari 2025 een adviesrapport uit over de toegang tot expertise van New Approach Methodologies (NAMs). Dit rapport, waarvoor TPI/LVVN de opdracht gaf, laat onder andere zien dat er grote behoefte is aan meer expertise over NAMs en, daarmee samenhangend, aan NAMs-experts. De resultaten zijn gebundeld in een adviesrapport aan TPI/LVVN.
Zie ook:
ZonMw lanceert in april 2025 de NAM Navigator, een kennisbank die helpt bij het navigeren door informatie over de ontwikkeling, standaardisatie, validatie en acceptatie van New Approach Methodologies (NAMs). Het fungeert als een gids die specifieke informatie biedt over deze stappen, waardoor het gebruik van proefdiervrije innovaties wordt vergroot.
ZonMw ontwikkelde de NAM Navigator in opdracht van het Ministerie van Landbouw, Visserij, Voedselzekerheid en Natuur (TPI).
Zie ook:
Op Wereldproefdierendag (24 april 2025) wint een team van wetenschappers met de naam HeartSmart de jubileumeditie van de Proefdiervrij Venture Challenge. Met het prijzengeld van 25.000 euro gaat het team hun proefdiervrije hartmodel op de markt brengen. De prijs wordt in het bijzijn van wetenschappers, ondernemers en studenten uitgereikt tijdens het jaarlijkse Proefdiervrij Event, dit jaar op een wel heel toepasselijke locatie: Corpus in Leiden.
Zoe ook:
Het 3Rs Centre Utrecht lanceert in mei 2025 de Basement Membrane Extract (BME)-free Database. Voor proefdiervrije innovaties zoals organoïden en pluripotente stamcellen gebruiken onderzoekers (nog) materialen die van dieren afkomstig zijn. Deze materialen zijn nodig om de cellen te laten groeien en differentiëren in bijvoorbeeld hersencellen of huidcellen.
Dit project wordt mede mogelijk gemaakt door Proefdiervrij.
Zie ook:
Het College van Bestuur van de Universiteit Utrecht benoemt Anne Kienhuis per 1 juni 2025 tot hoogleraar Toxicologie in Transitie bij de faculteit Diergeneeskunde van de Universiteit Utrecht. De leerstoel draagt bij aan verschillende transities in de toxicologie, zoals de transitie naar proefdiervrije innovaties. Anne Kienhuis: “Ons doel is om veiligheid van chemische stoffen en geneesmiddelen betrouwbaar te beoordelen zonder proefdieren.”
Zie ook:
De EU-Raad keurt in mei 2025 de Europese beleidsagenda voor onderzoek en innovatie voor de komende drie jaar goed. Onderdeel daarvan is het voorstel voor de ontwikkeling en implementatie van New Approach Methodologies (NAM's).
Nederland heeft, in nauwe samenwerking met de Europese Commissie, een sleutelrol gespeeld bij het opstellen van dit belangrijke initiatief en zal optreden als medevoorzitter. Deze onderzoeksagenda is een enorme kans om NAM's voor gebruik in biomedisch onderzoek en het testen van geneesmiddelen en medische hulpmiddelen nog beter op de Europese agenda te zetten.
Zie ook:
Binnen het programma Humane Meetmodellen gaan zes nieuwe projecten onderzoek doen naar doorontwikkeling van humane meetmodellen. De Samenwerkende Gezondheidsfondsen (SGF), ZonMw en Topsector Life Sciences & Health (Health~Holland) financieren gezamenlijk de projecten.
Humane meetmodellen zijn onderzoeksmodellen die de mens als uitgangspunt nemen, zoals humane cellen en weefsels op een chip of computermodellen die humane data gebruiken. Hiermee wordt het mogelijk om onderzoek beter voorspelbaar en sneller toepasbaar te maken voor de patiënt. Daarnaast zal de wetenschap door gebruik van deze modellen minder afhankelijk gaan worden van proefdieronderzoek.
Zie ook:
Mirjam Luijten, toxicoloog bij het RIVM, gaat per 1 juli 2025 aan de slag als bijzonder hoogleraar bij het LACDR (Leiden Academic Centre for Drug Research). Met haar leerstoel Humaan-relevante Risicobeoordeling van Chemische Stoffen richt zij zich op een innovatieve aanpak voor risicobeoordeling.
Het hoofdthema van de leerstoel die gefinancierd wordt door het RIVM is ‘next-generation risk assessment’, een innovatieve benadering om de veiligheid van chemische stoffen voor mensen te beoordelen. Voor het LACDR en Universiteit Leiden betekent de samenwerking met het RIVM meer kennis op het gebied van regelgeving voor chemische stoffen en goede mogelijkheden om fundamenteel onderzoek toepasbaar te maken voor beleid.
Nieuwsbericht 1 juli 2025: Luijten benoemd tot bijzonder hoogleraar Humaan-relevante Risicobeoordeling van Chemische Stoffen
Het hDMT wordt in juli 2025 de 12e partner van het TPI-partnerprogramma. Met de toevoeging van hDMT verwelkomt TPI een consortium, bestaande uit de stichting hDMT en 16 partnerorganisaties, waaronder (technische) universiteiten, universitair medische centra, een hogeschool en een kennis- en innovatie-instituut. Dit biedt vele mogelijkheden om proefdiervrije modellen sneller in de praktijk te implementeren.
In het partnerprogramma werken uiteenlopende organisaties samen met de overheid om de transitie naar proefdiervrije innovatie te versnellen.
Zie ook:
Op 7 juli 2025 vindt de lancering plaats van Ombion, Centrum voor Proefdiervrije Biomedische Translatie. Dit centrum wordt ondersteund door het Nationaal Groeifonds.
Ombion werd tijdens een feestelijke bijeenkomst in bijzijn van vele genodigden gelanceerd in het Life Science Incubator (LSI) gebouw op het Utrecht Science Park. De opening van het centrum en de onthulling van de nieuwe naam en het logo werden verricht door Marten van den Berg, directeur-generaal Agro van Landbouw, Visserij, Voedselzekerheid en Natuur, samen met Daniela Salvatori, wetenschappelijk directeur ad interim van Ombion.
Het eerder door het Ministerie van Landbouw, Visserij, Voedselzekerheid en Natuur ingediende CPBT Nationaal Groeifonds voorstel werd vorig jaar toegekend. Dit heeft nu geleid tot de oprichting van het centrum.
Zie ook:
In de subsidieronde Create2Solve (fase 2) honoreert ZonMw in juli 2025 twee unieke projecten: één voor de ontwikkeling van een in vitro model voor artritis en één voor de ontwikkeling en standaardisatie van complexe kweekmethoden met diervrije reagentia.
ZonMw stimuleert met het Create2Solve instrument de ontwikkeling van innovatieve, proefdiervrije methoden via publiek-private samenwerkingen. Juist de betrokkenheid van commerciële/industriële partners is een belangrijk uitgangspunt binnen Create2Solve. Dit om te stimuleren dat deze veelbelovende modellen niet alleen wetenschappelijk, maar ook commercieel waardevol kunnen worden. Beide projecten ontvangen 1 miljoen euro voor hun vervolgonderzoek.
Zie ook:
- Nieuwsbericht: Duurzame Doorbraak: Twee baanbrekende Create2Solve projecten gehonoreerd
- Create2Solve is onderdeel van het programma Meer Kennis met Minder Dieren
Nieuws

Twee Perspectief-projecten van NWO gaan bijdrage leveren aan meer onderzoek zonder proefdieren
Maar liefst twaalf consortia kunnen door het Perspectief-programma starten met hun onderzoeksprojecten gericht op het ...
15-12-20259:43Beeld: ShutterstockLees verder
TPI Labtour Amsterdam: de praktijk van onderzoek met humane en diermodellen
Op 10 november organiseerden we samen met TPI Amsterdam de tweede TPI Labtour. Vier laboratoria en het Proefdiercentrum Amsterdam ...
20-11-20258:39Beeld: TPILees verder
Helpathon Diervrij Onderzoek
Wat vind jij belangrijk als het gaat om beter onderzoek naar gezondheid en veiligheid voor mens, dier en milieu? Wat weet je van ...
17-11-20259:04Beeld: TPILees verder
Nieuwsbrief Terugblikken en Vooruitkijken
Terugkijkend zijn de afgelopen maanden intensief geweest voor TPI en alle betrokken partners en belanghebbenden. We hebben met ...
14-07-202513:08Beeld: TPILees verder
UITNODIGING TPI Labtour Amsterdam 10 november 2025
Ga je mee met de TPI Labtour Amsterdam op 10 november 2025? Ontdek zelf wat proefdiervrije innovaties zijn. En hoe een ...
10-07-202515:30Beeld: TPILees verder
Ombion Centrum voor Proefdiervrije Biomedische Translatie officieel gelanceerd
Vandaag is het door het Nationaal Groeifonds ondersteunde Centrum voor Proefdiervrije Biomedische Translatie officieel gelanceerd ...
07-07-202516:24Beeld: OmbionLees verder